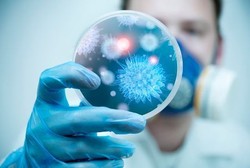
Mikrobia Berperan dalam Kemajuan Peradaban Manusia

detikFood
'All You Need is Cheese', Serba Keju untuk Segala Jenis Makanan
Keju, produk olahan susu ini sudah ratusan tahun dikenal sebagai pelengkap nutrisi manusia. Karena rasanya yang gurih enak, kaju diolah menjadi beragam makanan. Dari isian roti dan cake, saus, topping atau aneka dessert lezat.
Jumat, 21 Feb 2014 07:31 WIB